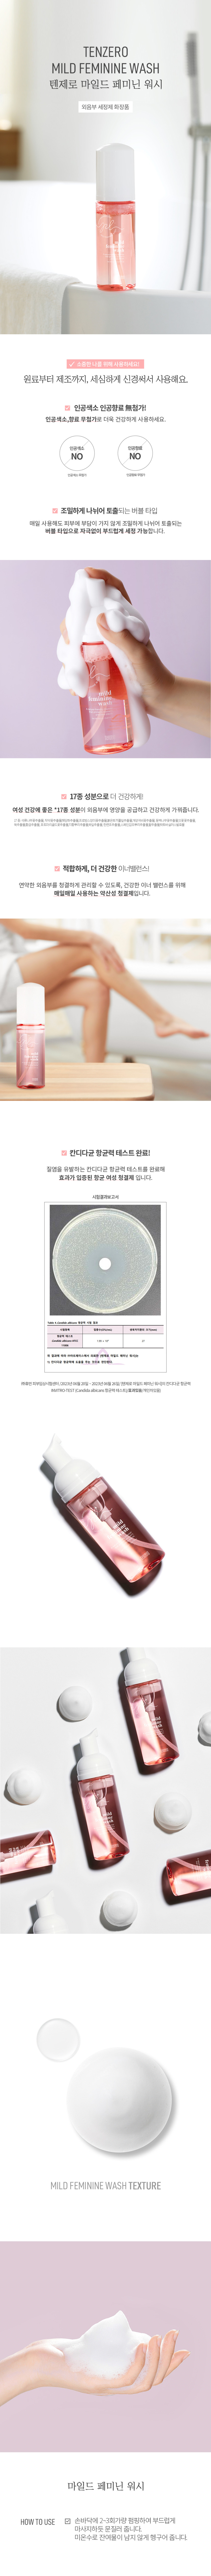
7a30f1d80e22d526c93f067a98c40f0c_1769594970_1587.jpg

관련상품
상품 정보
| 제품소재 | 상품페이지 참고 |
|---|---|
| 색상 | 상품페이지 참고 |
| 치수 | 상품페이지 참고 |
| 제조자 | 상품페이지 참고 |
| 세탁방법 및 취급시 주의사항 | 상품페이지 참고 |
| 제조연월 | 상품페이지 참고 |
| 품질보증기준 | 상품페이지 참고 |
| A/S 책임자와 전화번호 | 상품페이지 참고 |
상품 상세설명


사용후기
등록된 사용후기
사용후기가 없습니다.
상품문의
등록된 상품문의
상품문의가 없습니다.
| 제품소재 | 상품페이지 참고 |
|---|---|
| 색상 | 상품페이지 참고 |
| 치수 | 상품페이지 참고 |
| 제조자 | 상품페이지 참고 |
| 세탁방법 및 취급시 주의사항 | 상품페이지 참고 |
| 제조연월 | 상품페이지 참고 |
| 품질보증기준 | 상품페이지 참고 |
| A/S 책임자와 전화번호 | 상품페이지 참고 |